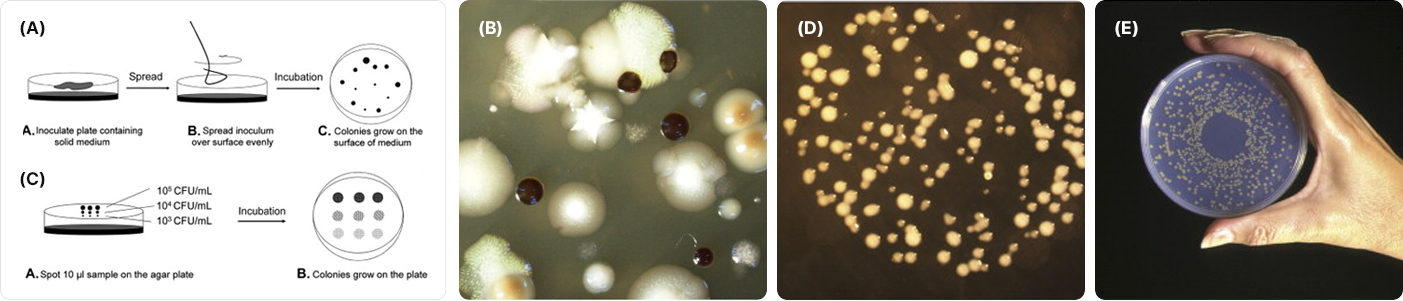

분석/연구용역 간편상담
담당 연구원 확인 후
연락드리겠습니다.
24시간동안 이 창을 열지않음
분석/연구용역 간편상담
담당 연구원 확인 후
연락드리겠습니다.
24시간동안 이 창을 열지않음
Microbiology 연구
생명공학 분야의 선두주자로서 신뢰성 있는 연구성과를 제공합니다.Research Field 01
Microbiology 연구

01자원미생물연구
01미생물을 이용한 산업
농업 바이오 산업 분야 : 토양 미생물

토양 미생물은 전 지구상에 존재하는 생물종의 60%를 차지하고 있습니다. 현재까지 알려진 미생물 종은 1% 미만 밖에 되지 않으며 나머지는 여러가지 이유로 발견되지 않은 채 자연계에 생존합니다. 배양 되지 않은 미생물은 유전체 분석을 통해 존재가 확인됩니다. 이처럼 토양은 '자원의 보물창고'로 불리고 있습니다.
토양 미생물 연구는 농업 바이오 분야에서 광범위하게 적용됩니다. 미생물은 토양을 복구하고 토양 활력을 회복하며 중금속 오염을 줄이며 2차 오염을 일으키지 않습니다. 미생물은 또한 물을 정화하고 공기에서 독성 가스를 제거할 수 있습니다. 농업에서 미생물의 가장 중요한 역할은 토양 속 각종 미생물이 유기물을 분해하여 식물에게 영양소를 공급해주며, 질산생성작용과 황·철·망간 등 무기 원소의 산화에 관여하여 토양의 물질순환을 담당합니다. 특히 토양미생물은 천연 유무 기질 비료의 역할을 하며, 뿌리의 호흡을 촉진하여 토양의 통기성을 좋게 만들어주어 작물의 수확량이나 토양 개량에 영향을 주기도 합니다.
화이트 바이오 산업 분야 : Bioremediation (생물적 환경 정화)대표적인 예) 플라스틱 분해 인공미생물

플라스틱의 사용이 증가함에 따라 폐기물의 발생량이 증가하고 있으며, 플라스틱의 무분별한 폐기로 인해 바다로 유입되는 플라스틱 산이 생기고 해양으로 유입된 플라스틱이 작은 입자로 쪼개지면서 유해성분이 어류의 먹이사슬을 통해 순환되고 유해성분으로 오염된 어류를 인간이 섭취하면서 건강에 위험을 유발하게 되는 악순환의 고리가 생성됩니다. 이러한 문제를 해결하기 위한 방안으로 커피 전문점, 제과점, 대형마트, 유통물류업계에서 플라스틱 용품의 사용을 감축하고 플라스틱을 분해하여 포장블록, 옷, 운동화 등으로 재활용하거나 플라스틱 분해 미생물을 이용하여 플라스틱을 분해하는 방법에 대해 연구가 진행되고 있으며, 리사이클(recycling)과 업사이클(upcycling)이라는 새로운 산업이 각광을 받고 있습니다.
플라스틱 분해 인공미생물은 2016년 케이오주쿠대 고분자연구팀의 요시다 쇼스케 연구팀에서 이데오넬라 사카이엔시스(Ideonella sakaiensis)를 발견하였으며, 이 박테리아가 첫 번째 효소(PETase)를 이용하여 PET(polyethylene terephthalate)를 MHET로 분해하고 두번째 효소(MHETase)를 이용하여 MHET를 분해 에너지를 얻는다고 발표하였습니다. 한국생명공학연구원은 이데오넬라 사카이엔시스에서 유래한 효소를 이용해 식물성 플랑크톤을 개발하여 페트병이 테레프탈산과 에틸렌클라이콜로 분해되어 미세플라스틱이 해양생태계에 쌓이는 문제를 해결할 것이라고 기대하고 있습니다.
02미생물 분리 및 동정
다양한 미생물을 분리하기 위해서는 목적에 맞는 배양환경을 만들어 미생물을 환경으로부터 분리하여 배양하는 기술이 필수적입니다. 미생물이 존재하는 시료로부터 목적으로 하는 미생물을 분리하는 것을 순수분리라고 하며, 한종류의 미생물만을 배양하는 것을 순수배양이라고 합니다. 미생물자원화를 위해서는 보통 다섯 가지 기본적인 방법을 사용합니다.
접종(inoculation)
미생물의 접종은 배양을 위한 선행 과정으로서 시료(inoculum)를 미생물들이 증식할 수 있는 배지에 심는것을 말합니다.이때 시료는 배양시키기 원하는 미생물 개체를 가리키는 말인데 각각의 미생물들은 일반적으로 독특한 배양 환경을 갖기 때문에 원하는 시료의 성공적인 배양을 위해서는 배양 환경을 적절히 조절 및 통제해야 합니다.
배양(incubation)

어느 한 배지에 접종시킨 후, 시료 속에 있는 미생물 개체를 성장 및 번식하게 하는 과정을 배양이라고 합니다. 접종 시에는 보이지 않았던 미생물은 배양을 통해서 성장 및 번식하여 눈으로 보이게 됩니다. 이때 눈으로 보이는 배지 속 미생물의 모습은 일반적으로 동그란 집락을 형성하는데 이를 콜로니(colony)라고 합니다. 배양을 성공적으로 수행하기 위해서는 미생물의 종의 특성에 맞춰 온도나 pH 및 그 밖의 배양 환경을 알맞게 유지시켜줘야 합니다.
분리(isolation)

순수분리는 평판배지를 사용하여 혼합 배양균에서 순수한 독립집단(single colony)를 배양하기 위하여 미생물을 배양하는 것입니다. 여러 종류의 균이 들어있는 시료에서 원하는 균종 하나만을 선택적으로 다른 배지에서 키워내 순수하게 한 가지의 종만을 배양합니다. 고체배지를 이용하여 미생물을 순수분리하기 위한 방법은 크게 획선평판법, 도말평판법, 주입평판법이 있다. 획선평판법(streak plate method)은 배지 표면에서 미생물 군집을 분리하기 위해 백금이를 이용하여 한천 배지 표면에 미생물을 획선으로 도말하는 방법입니다. 도말평판법(spread plate method)은 희석된 균주를 고체배지 표면 위에서 도말봉을 이용하여 도말합니다. 주입평판법(pour plate method)은 희석된 균주를 petri dish에 주입하고 혼합하여 평판을 만드는 방법입니다.
검사(inspection)

위의 과정에서 얻어진 순수한 콜로니, 혹은 액체배지 배양액으로부터 시료를 분석하기 용이해집니다. 검사는 관찰하기 용이해진 시료를 현미경 과찰, 염색법 등을 통하여 미생물의 특성을 조사하는 과정입니다. 현미경 관찰을 통해서는 미생물의 운동성, 크기, 색 등을 확인할 수 있으며, 염색법으로는 시각적 관찰을 더 용이하게 할 뿐만 아니라 개체 수, 생사의 유무, 특정 미생물의 분류 등을 알아낼 수 있습니다. 염색법에는 여러 가지가 있지만 대표적으로 단염색법, 그람염색법 등이 있습니다.
동정은 대상 미생물의 종을 판별하여 어떠한 특성이 있고 어디에 속하는지를 알아내는 것입니다. 균주의 동정법은 고전적인 방법으로 형태적, 배양적 특성인 속(genus) 만을 동정 할 수 있으며, 종(species)까지 최종적으로 규명하기 위해서는 생리·생화학적 조사가 필요합니다. 따라서 형태적 특징 및 배양의 특징만으로 세균의 속, 종, 특성을 관찰하기는 어렵기 때문에 미생물마다 나타내는 생리·생화학적 대사를 관찰하여 미생물에 따라 나타나는 특이한 효소 작용을 알아내어 미생물 동정 및 분류에 이용할 수 있습니다.
Metagenome 분석

NGS 분석(Next Generation Sequencing, 차세대 염기서열 분석)은 유전체의 염기서열의 고속 분석 방법입니다. NGS는 라이브러리 구축 및 클로닝 과정을 거치지 않고 PCR(Polymerase Chain Reaction)로서 바로 증폭하여 주형(Template) DNA의 클론을 얻는 클론 증폭(Clone amplification) 과정을 거치면서 획기적으로 시간을 단축하였고, 대량 병렬 방식(Massively parallel)을 도입하여 동시에 수십만 개의 클론을 취급할 수 있도록 하여 효율을 향상 시키는 것은 물론 주형 DNA의 서열정보를 바로 읽는 새로운 방법입니다.
Reference 기반 유전체 분석은 표준 유전체(Reference genome)가 완성된 생물종의 유전체 서열 정보를 기반으로 표준 유전체 서열과 비교함으로써 특정 유전체 내 변이를 발굴하고자 할 때 주로 쓰입니다. 즉, 이미 알려진 서열정보를 참조로 하여 시료의 염기서열 해석 결과를 비교 확인하는 방법입니다. 미생물학계에서는 단일 생물종의 유전체 해독 연구를 넘어서서, 특정 환경에서 수집한 샘플에 함유된 유전체를 분석함으로써 각 환경의 미생물 군집을 파악하고하 하는 metagenomics 연구가 활발히 수행되고 있습니다.
Whole metagenome shotgun 분석 방법
16S rDNA metagenome 분석 방법
한국의과학연구원 미생물자원화센터는 자원미생물 연구를 수행하며 지속적으로 신규 미생물의 확보와 유용미생물 활용의 확립을 통해 최신 기술을 개발·진행하고 있습니다. 또한 유용미생물센터나 대학과 연계하여 유용미생물에 관한 실험적인 정보를 얻어 실제 생활에 이용하여 긍정적인 연구 결과를 보고 있으며 농업, 임업, 어업, 축산업, 환경 및 의학 분야와 협업하여 연구를 활발하게 수행하고 있습니다. 특히 연구소에서는 전통적인 배양방식 및 DNA분석을 통한 동정(Identification)을 진행하기 전에 대상이 되는 시료에 대해 먼저 Metagenome관점으로 목표하는 미생물의 DNA흔적이 있는지를 확인하는 Pre-metagenome screening기술을 개발하여 자원미생물발굴에 드는 시간과 비용을 획기적으로 개선하여 관련 기관 및 기업에 도움이 되고 있습니다.

02친장환경제품연구

GFP(Gut Friendly Product) Mark [KRIBS-DF12-REV.O] 국내최대 장내환경 분석/연구기관인 한국의과학연구원에서 운영하는 인증제도로 腸內細菌개선에 대한 유효성이 입증된 제품에 부여하는 인증입니다.
전통적으로 프로바이오틱스 제품들은 Lactobacillus 등의 유산균을 이용하여 만들어진 발효유 제품으로 섭취되어 왔으나 최근에는 Lactobacillus 이외에 Bifidobacterium, Enterococcus 일부 균주 등을 포함한 발효유뿐 아니라 과립, 분말 등의 다양한 형태로 판매되고 있습니다. 온라인 쇼핑몰에서 찾아볼 수 있는 제품수만 5만여 개, 소비자들은 프로바이오틱스를 구매하기도 전에 '선택 스트레스'에 시달리게 됩니다.
그럴수록 따져봐야 할 점은 섭취한 유산균이 장에서 잘 활동 하는가입니다. 오늘날은 제품의 과대·과장 광고 때문에 소비자가 직접 세밀히 따져보지 않으면 일부 소수 체험자의 경험과 느낌이 확대 재해석 되거나 반대로 참으로 유용한 제품임에도 불구하고 그 유효성을 명쾌하게 입증하지 못해 평가절하되는 경우가 발생합니다. 이렇듯 제품 검증의 필요성이 높아지고 있는데 이에 한국의과학연구원 마이크로바이옴센터는 시판되어 소비되는 제품의 유효성에 대한 프로세스를 정립하고 이에 다양한 산·학·연 기관과 장건강 유효성을 확인하는 연구 활동을 하고 있습니다.
친腸환경 제품 인증 절차(Process)

GFP 인증 진행을 위한 사전실무협의 및 협약
(상호기밀유지서약포함)

제품 섭취 전,
실험그룹의장내세균상태 측정

친腸환경 인증 추진 대상제품
일정기간 복용

제품 섭취 후,
실험그룹의 장내세균변화 측정

실험결과에 대한
유효성 평가

GFP 제품 인증
심의 및 심사

GFP 제품 인증
및 인증서 부여
위와 같은 유효성 평가는 시판되어 일반인들이 이미 활용하고있는 제품으로 그 범위를 한정하여 안정성을 확보하지만 그 유효성 확인과정에서도 철저한 확인 절차와 과학적인 검증을 거쳐야 객관적인 유효성 확인이 가능해집니다. 수많은 분석을 통해 쌓은 장내세균 데이터와 연구를 통해 밝혀진 안정된 장(腸) 플로라를 유지하는 균의 비율값을 기준으로 비교 분석되어 효과적인 제품에 한해서만 검증이 됩니다. 마이크로바이옴 분야의 급속한 발전으로 이제 소비자는 제품의 유효성을 확인하고 먹을 수 있는 시대가 도래하고 있습니다.
한국의과학연구원 마이크로바이옴센터는 철저하게 효과 확인된 제품에 대해서 친장환경제품(GFP : Gut Friendly Product)인증을 부여하여 그렇지 않은 제품과 차별을 두어 소비자들이 손쉽게 검증된 우수제품을 선택할 수 있도록 돕습니다.
